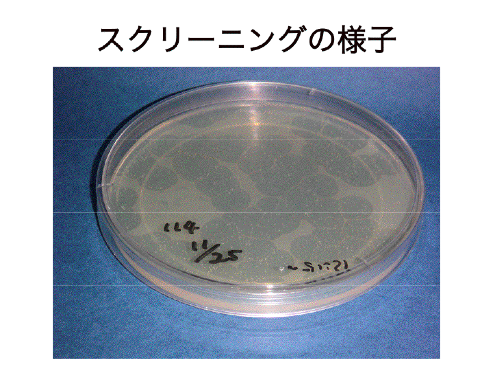

遺伝学的サプレッサー解析によるSTATa制御シグナルの解明
ある遺伝子に変異を持った変異体があるときに、それとは独立の2番目の変異が起こることによってかえって表現型が野生型に近くなるときに2番目の変異のことをサプレッション、また変異が入った遺伝子のことをサプレッサーといいます。変異の種類はloss-of-functionの場合もあればgain-of-functionの場合もあります。また、サプレッションが起こる原因も下図に示すようにさまざまです。しかしながら、ある遺伝子の変異体があるとき、その遺伝子と全く関連を持たない遺伝子がサプレッションを起こすとはまず考えられません。サプレッサーがあるとすれば、必ずやどこかで繋がっていると考えるのが普通です。

そこで、このような方法を用いて細胞性粘菌でもサプレッサーをとろうと試みました。細胞性粘菌においてはloss of function変異体をスクリーニングするREMIという方法が確立されていましたが、この方法は変異体から遺伝子を単離するのに少々時間を要してしまうのと費用もかさんでしまうので、何とか別の方法を考えることにしました。細胞性粘菌ではcomplementationなどによるスクリーニングはほとんどなされていなかったのですが、こちらに赴任した当時Stanford大学のSpudichのところにいたDoug
Robinsonが唯一そのような方法でスクリーニングに成功していました。我々も彼の方法に従い、我々の遺伝子STATaに合わせた系を組み立てることにしました。まず、Dougとは時期が違うのでcDNAライブラリーの構築から行いました。

ライブラリー作製に用いたベクターはこちら(上図)。実は、このベクターには見覚えがありました。イギリスに留学当時、やはり同じようなことをゲノムライブラリーでやっていた人がいて、Lucy Druryという姉さんでした。その人にとてもお世話になったのですが、pLDはその頭文字から来ていてそれが巡り巡ってStanfordに行って改良されたのがおそらくこれです。cDNAライブラリーの作製にはイギリスで充分に修行を積ませてもらったので、ほどなくとても良いライブラリーが出来上がりました。リクエストが多いので、既に世界中にばらまきました。こっちにはそんなに残ってないので皆さんもう請求しないで下さい。前置きが長くなりましたが、このベクターはレプリカーゼ存在下で安定に多コピー存在出来るような複製起点を持っています(Ddp2-ori)。従って、細胞内で多コピー存在しcDNAは過剰発現されることになります。もし、あるcDNAがその遺伝子がコードするタンパク質の機能をすべてカバーしているならば、いわゆるマルチコピーサプレッサーとして単離されてくることになります。もし、重要な機能ドメインを欠いている場合はdominant negative mutantとしてとれてくることもあり得ます。
スクリーニングの親株としてはレプリカーゼの遺伝子をゲノムに挿入してやる必要があるので、少々やることがありますが、親株が出来ればサプレッションのスクリーニングは下図のように子実体を作るか作らないかを目印に行います。

(島田さん原図、平成16年度東邦大学修士論文より)
さて、実際のスクリーニングですが、最初はSTATa遺伝子破壊株にレプリカーゼ遺伝子を導入したものを親株に用いました。想像は出来たのですが、この方法でサプレッサーをクローン化することには成功しませんでした。理由は、STATaは転写因子で非常に多くの重要な遺伝子の発現を制御しており、cDNAクローンを1つ過剰発現させただけではSTATa遺伝子破壊株の表現型をサプレッションするのは難しいと考えられるからです。そこで、何とか弱い表現型を持ったSTATaの変異体は作れないものかどうか考えました。現在弘前大学にいる福澤先生がSTATaのN末端欠損タンパク質を作るコンストラクトを持っていました(下図)。

このコンストラクト(aL)を、先の親株に1コピーのみ導入すると不完全な子実体を作るようになりました(下図)。寒天培地上ではちょっとしか子実体を形成しません。さらに、さまざまなマーカー遺伝子等の発現状況から、このコンストラクトを導入した株は「STATa遺伝子部分破壊株」と呼んでもよい性質を有していることがわかりました(Shimada and Kawata, 2007)。この株を用いて、今までに数十万クローンをスクリーニングしたところ、「STATa遺伝子部分破壊株」よりも表現型が野生型に近くなるクローンが14個得られました。それぞれの機能については現在解析中で、わかり次第報告します。このような分子遺伝学的方法で、大規模スクリーニングを行いSTATのサプレッサーをクローン化した例は他のモデル生物でも例がありません。

(島田さん原図、平成16年度東邦大学修士論文より)
この写真は、こんなふうにスクリーニングしているというイメージです。本当のスクリーニング用のプレートではありません。背景が透けて見えるところがプラークで、もともと1個の細胞性粘菌の細胞が増殖して周りのバクテリアを食べたものです。実際のスクリーニングでは、1枚のプレートあたり300クローンくらいになるように細胞をまき、プラークの中央部の多細胞体の形態を実態顕微鏡で観察します。地道な作業です。サプレッサーは子実体の数が多くなったり、柄が長くなったり(野生型に近くなる)するので容易に判別出来ます。
現在のところ、スクリーニングした数はライブラリーのcomplexityに比べて遥かに小さい状況です。従って、充分にスクリーニングしたとはとてもいいがたい状況です。とても大事なサプレッサーをとり逃している可能性は充分にあるので、これからもスクリーニングを続けていく必要があります。
なお、副産物として直接サプレッサーではないけれども形態形成がおかしくなるクローンがとれてきますが、今のところ詳しい解析は全然やっておりません。